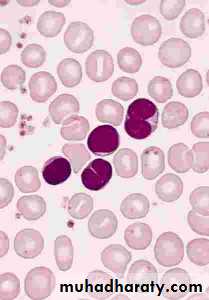

Pertussis
Hasanein Ghali, MD - Department of PediatricsCollege of Medicine – University of Baghdad
December, 29th, 2015
EPIDEMIOLOGY
The vast majority of outbreaks of Pertussis are caused by the bacterium Bordetella pertussis.Pertussis syndrome ;paroxysmal coughing, can be produced by related bacteria and several types of adenovirurus.
Transmission requires close contact with a case.
healthy carriers are rare but adolescents and adults who have pertussis may have relatively minor symptoms and be contagious.
The incubation period is 7 to 10 days.
SYMPTOMS AND SIGNS
SYMPTOMS AND SIGNS (cont.)These bouts of coughing gradually increase in severity, requiring hospitalization of infants and younger children.
The child may become cyanotic during the struggle to take a breath and clear thick mucus secretions.
Vomiting is common at this time.
Gentle suctioning and positioning will help air exchange.
3- Convalescent Stage: Symptoms gradually diminish over 2 to 4 weeks, and the patient returns to normal.
The clinical course is not altered dramatically by the administration of antibiotics or other medications.
COMPLICATIONS
• Pneumonia due to the Pertussis organism or, more frequently, to secondary bacterial invasion is a common complication and a major contributor to the death of infants and young children who become hypoxic and may have intracranial hemorrhages.
• Other, less serious complications include otitis media, subconjunctival hemorrhage, and electrolyte abnormalities.
LABORATORY DIAGNOSIS
• Most patients who have Pertussis are diagnosed clinically because of the paroxyms of cough, especially when accompanied by whoop.• Diagnosis in the early stage of disease may be made by culturing nasopharyngeal secretions.
TREATMENT
Infants younger than 6 months of age who have severe paroxysms and difficult feeding or difficult handling secretions may require hospitalization.Antimicrobials given early may moderate symptoms, but they are of little benefit in the paroxysmal stage except to limit spread of organisms.
Erythromycin 40 to 50 mg/kg in four divided oral doses is the drug of choice.
Corticosteroids, and albuterol have been used in the management of pertussis.
PREVENTION
• Protective antibody to pertussis does not cross the placenta. This means that the newborn is completely vulnerable to infection.• Pertussis vaccine provides protection against whooping cough. The immunity probably is not as long-lasting as that following natural disease.
The immunization of the normal infant begins at the age of 2 months , repeated at 8-week intervals for a total of three doses with a combined vaccine (DPT).
Boosters are administered at ages 12 to 18 months and 4 to 6 years.
CONTROL OF OUTBREAKS
Varicella
Name !!!The name chickenpox has been around for centuries, it's from the blisters that are seen with the illness. These red spots were once thought to look like chickpeas (garbanzo beans). Another theory is that the rash of chickenpox looks like the peck marks caused by a chicken.
DEFINITIONS
• Disseminated zoster in immunocompromised patients consists of severe rash with systemic findings.• Congenital varicella syndrome, or varicella embryopathy, is the result of varicella infection in a woman during the first or second trimester of pregnancy.
EPIDEMIOLOGY
Varicella infection is more common during the late winter and early spring.
The mode of transmission is person to person via direct contact with infected mucosa or airborne particles from respiratory secretions. Trans placental passage of the virus also can occur.
Immunity after natural varicella infection is considered lifelong.
The incubation period is 10 to 21 days.
Communicability is highest from 2 days prior to rash to 2 days after its onset.
Susceptible Healthy children may be considered noncontagious after all lesions have crusted over, although communicability may be prolonged in immunocompromised patients who have severe infection.
children may become infected with varicella after direct contact with active zoster lesions because these lesions contain infectious virus.
EPIDEMIOLOGY
PATHOGENESIS• After a person is exposed to VZV, the virus undergoes two phases of replication during the incubation period.
• Primary replication, 3 to 4 days after exposure, occurs in the oropharynx and regional LN, followed by a primary viremia.
• A secondary viremia, with intracellular replication within the reticuloendothelial system, occurs 10 to 21 days after exposure.
• Late in the secondary viremic phase, the virus is delivered to the skin, at which time the typical cutaneous lesions become evident.
PATHOGENESIS
The virus also is carried to the respiratory mucosa toward the end of the incubation period, which is the reason for communicability before the onset of rash.Following viremia, the virus becomes latent in dorsal root ganglia cells. It remains there until reactivation, at which time the virus travels back to the skin along the sensory nerve.
Reactivation likely is due to declining cell-mediated immunity, which explains the increased incidence in the elderly and in immunocompromised patients.
CLINICAL PRESENTATION
The rash of varicella often is preceded by a 24 – 48 hrs period of fever, malaise, and other systemic symptoms.
The typical exanthem begins as erythematous, pruritic macules that develop into papules and fluid-filled vesicles.
The crusting of the vesicles is the final stage of the lesions before resolution, and scarring occurs rarely.
One of the most characteristic features of the exanthem is the presence of all stages of lesions simultaneously.
• CLINICAL PRESENTATION
CLINICAL PRESENTATIONCongenital varicella syndrome results when a mother is infected within the first 20 weeks of gestation. “Zigzag” skin scarring and limb atrophy are characteristic findings of this embryopathy.
Brain abnormalities, including hydrocephalus and microcephaly, and eye abnormalities, such as cataracts and chorioretinitis, also may occur.
COMPLICATIONS
Herpes Zoster• The most common sites are those supplied by the trigeminal nerve and the thoracic ganglia.
• New lesions occur over 2 to 3 days, then begin to crust over the next week. Lesions resolve within 2 weeks.
• The most common complication of herpes zoster is postherpetic neuralgia, which is defined as pain that lasts longer than 1 month. This is uncommon in children.
DIAGNOSIS
The clinical appearances of primary varicella and herpes zoster infections are so characteristic that laboratory testing often is not necessary.A Tzanck smear performed on a vesicle scraping shows multinucleated giant cells, but it does not distinguish between zoster and herpes simplex.
Viral culture, direct fluorescent antigen and PCR performed on a vesicle scraping are of diagnostic help.
TREATMENT
• The use of acyclovir is not routinely recommended for healthy children younger than 12 years of age because the disease generally has a benign, self-limited course.
TREATMENT (cont.)
• Oral acyclovir may be considered for those at risk for more severe infection, including• children older than age 12 years,
• persons who have chronic disease and
• persons who are taking chronic aspirin or corticosteroid therapy.
• Intravenous acyclovir should be used for immunocompromised patients who have varicella-zoster infection and should be initiated within 24 hours of the onset of the rash.
Varicella vaccine and varicella-zoster immune globulin (VZIG) are both available for the prevention of disease in susceptible persons exposed to VZV.
• Significant exposure includes
• household contacts,
• close play or
• hospital contacts,
• newborns born to mothers who develop varicella 5 days prior to or 2 days after delivery, and
• those who have direct contact with active zoster lesions.
POST EXPOSURE PROPHYLAXIS
ISOLATIONAirborne and contact precautions should be initiated for hospitalized patients at least 5 days after the onset of the rash and maintained until all vesicles are crusted.